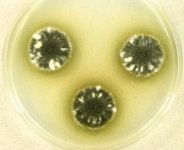

Search Details
| UAMH Number: | 6417 |
|---|---|
| Species Name: | Stachybotrys chlorohalonatus |
| Type: | |
| Synonyms: | Stachybotrys chlorohalonata |
| Taxonomy: | FUNGI Ascomycota, Sordariomycetes, Hypocreales, Stachybotryaceae |
| Strain History: | J. Krug -> Khan, R.S. (N-17) -> UAMH |
| Substrate: | desert sand | Location: | NAMIBIA SE of Swakopmund, nr Gobabeb (GEO: -23.56,15.04) |
| Isolator: | (C) J. Krug |
| Isolation Date: | 1986-01-07 |
| Date Received: | 1989-05-24 |
| Characters: | APPLICATION quantitative PCR analysis of house dust for Stachybotrys chartarum - Meklin T, Haugland RA, Reponen T, Varma M et al, J Environ Monit 6:615-620, 2004 // MOLECULAR SYSTEMATICS detection and phylogeny of Stachybotrys - Haugland & Heckman, Molecular & Cellular Probes 12:387-396, 1998 // MOLECULAR SYSTEMATICS hemolysis, toxicity & RAPD analysis - Vesper et al., Appl. Env. Microbiol. 65:3175-3181, 1999 // MOLECULAR SYSTEMATICS PCR assay for specific detection - Black JA, Dean TR, Foarde K, Menetrez M, Mycol Res 112:845-51, 2008 // MOLECULAR SYSTEMATICS PCR assay for specific detection - Haugland, Vesper & Wymer, Molecular & Cellular Probes 13:329-340, 1999 // MOLECULAR SYSTEMATICS phylogenetic relationships of Memnoniella & Stachybotrys - Castlebury LA, Rossman AY, Sung G-H, Hyten AS, Mycol. Res. 108:864-872, 2004 // MOLECULAR SYSTEMATICS phylogenetic relationships of Memnoniella & Stachybotrys - Haugland, Vesper & Harmon, Mycologia 93:54-65, 2001 // MOLECULAR SYSTEMATICS UAMH 3228, 6417, 6425, 7720 and ATCC 9182 have same ITS2 sequence but differ by one bp from other Stachybotrys - Haugland & Heckman, Molecular & Cellular Probes 12:387-396, 1998 // PIGMENT green on CYA after 7d @ 25C - (Click for publications citing UAMH 6417) |
| Compounds: | |
| Cross Reference: | ATCC 66238 // EPA 388 // N-17 // NC-8 |
| Collections: | Living Strains; Dried Herbarium Material |
| Pathogenic Potential: | Human: yes | Animal: no | Plant: no |
| Biosafety Risk Group: | RG2 (check the PHAC ePATHogen Risk Group Database for updates) |
| Regulatory Requirements: | Canadian requesters must provide PHAC Pathogen and Toxin License Number (see: https://www.canada.ca/en/public-health/services/laboratory-biosafety-biosecurity/licensing-program.html) prior to shipment. International requesters must provide all legally required importation documentation prior to shipment. Plant pathogenicity status may be verified by using the USDA Agricultural Research Service (ARS) Fungal Database |
| MycoBank ID: | 626958 |
| Sequences: | >UAMH06417_AY489573_ATPsyn GAGAGATATCTTAAATTTAGAAATATTAAGTGCTAATTTACAAATATCTTTAACTAATATAGGATTCTATTTAACATTAGGTGCTATAATTATATTAGGTTTAAGTATATTAGCAACAAATTATAACAAATTAGTAAGTAACAATTGATCTATAGCTCAAGAATCTTTATATATGACTATACATGGTATAGTTACAAATCAAATTAATGCAAAAAATGGTCAAATTTATTTCCCATTTATTTATACTTTATTTATATTTATCTTAATTAATAATTTAATAGGTATGATACCTTATAGCTTTGCTTCAACTAGTCACTTTGCTTTAACATTTGCTCTTAGTTTTACAATAGTATTAGGTGCAACTATACTTGGATTTTCTAGACACGGTTTAAAATTCTTTTCATTGTTAGTACCAGCTGGTTGCCCTTTACCTCTTTTACCTTTATTAGTTACAATTGAATTAATATCATATTTAGCTAGAAATGTTTCTCTAGGTTTAAGATTAGCTGCAAATATTACAGCTGGGCATATGTTATTAAGTATCTTAAGTGGTTTCGTTTATAATATCATGAATTCAGGAATTATATTTTTTATTGTGGGATTAATACCTTTATTATTTATAATAGCCTTTTCAGGTTTAGAATTAGCCATAGCCTTTA >UAMH06417_AY489607_EF1a ATTACTGGTACTTCCCAGGCCGACTGCGCTATCCTCATTATCGCTGCCGGTACTGGTGAGTTCGAGGCTGGTATCTCTAAGGATGGCCAGACCCGTGAGCACGCCCTGCTTGCCTACACCCTTGGTGTCAAGCAGCTCATCGTCGCCATCAACAAGATGGACACCACCAACTGGTCTGAGGCCCGTTTCCAGGAGATCATCAAGGAGACCTCCAACTTCATCAAGAAGGTCGGCTACAACCCCAAGACCGTTGCCTTCGTCCCCATCTCCGGCTTCCACGGCGACAACATGCTGGCTCCCTCCGCCAACTGCGGTTGGTACAAGGGCTGGGAGAAGGAGACCAAGGGTGGCAAGTCCACTGGCAAGACCCTCCTCGAGGCTATCGACTCCATCGAGCCCCCCAAGCGTCCCACCGACAAGCCCCTCCGTCTTCCCCTCCAGGACGTCTACAAGATCGGCGGTATTGGCACAGTTCCCGTCGGCCGTATCGAGACTGGTGTCCTCAAGCCCGGTATGGTCGTTACCTTCGCTCCCTCCAACGTCACCACTGAAGTCAAGTCCGTTGAGATGCACCACGAGCAGCTCCCTGAGGGCAACCCTGGTGACAACGTCGGCTTCAACGTGAAGAACGTTTCCGTCAAGGAAATCCGTCGTGGTAACGTTGCTGGTGACTCCAAGAACGACCCCCCTATGGGTGCCGCCTCTTTCCAGGCCCAGGTCATCGTCCTGAACCACCCCGGTCAGGTTGGTGCTGGATACGCCCCAGTTCTTGACTGCCACACCGCCCACATTGCTTGCAAGTTCGCCGAGATCCAGGAGAAGATCGACCGCCGAACTGGCAAGTCTGTTGAGTCTGCCCCCAAGTTCATCAAGTCTGGTGACTCTGCCATCGTCAAGATGGTTCCCTCCAAGCCCATGTGCGTTGAGGCTTTCACCGACTACCCTCCCCTGG >UAMH06417_AY489712_LSU GAAAAGAAACCAACAGGGATTGCCTTAGTAACGGCGAGTGAAGCGGCAACAGCTCAAATTTGAAATCTGGCCCCAGGCCCGAGTTGTAATTTGCAGAGGATGCTTTTGGCGCGGTGCCTTCCGAGTTCCCTGGAACGGGACGCCATAGAGGGTGAGAGCCCCGTCTGGTTGGATACCAAGCCTTTGTAAAGCTCCTTCGACGAGTCGAGTAGTTTGGGAATGCTGCTCTAAATGGGAGGTATATGTCTTCTAAAGCTAAATACCGGCCAGAGACCGATAGCGCACAAGTAGAGTGATCGAAAGATGAAAAGCACTTTGGAAAGAGAGTTAAACAGCACGTGAAATTGTTAAAAGGGAAGCGTTTATGACCAGACTTGGGCCGGTTAATCATCCAGCGTTCTCGCTGGTGCACTTTGCCGGTCCAGGCCAGCATCAGTTCGCTGCGGGGGATAAAGGCGTCGGGAATGTGGCTCCTCCGGAGTGTTATAGCCCTTCGCGCAATACCCTGCGGTGGACTGAGGTTCGCGCATCTGCAAGGATGCTGGCGTAATGGTCATCAACGACCCGTCTTGAAACACGGACCAAGGAGTCGTCTTCGTATGCGAGTGTTCGGGTGTAAAACCCCTACGCGTAATGAAAGTGAACGCAGGTGAGAGCTTCGGCGCATCATCGACCGATCCTGATGTTCTCGGATGGATTTGAGTAAGAGCATACGGGGCCGGACCCGAAAGAAGGTGAACTATGCCTGTATAGGGTGAAGCCAGAGGAAACTCTGGTGGAGGCTCGCAGCGGTTCTGACGTGCAAATCGATCGTCAAATATGGGCATGGGGGCGAAAGACTAATCGAACCTTCTAGTAGCTGGTTTCCGCCGAAGTTTCCCTCAGGATAGCAGTGTTGAACTCAGTTTTATGAGGTAAAGCGAATGATTAGGGACCCGGGGGCGCTATTTAGCCTTCATCCATTCTCAAACTTTAAATATGTAAGAAGCCCTTGTTGCTTAATTGAACGTGGGCATTCGAATGTATCAACACTAGTGGGCCATTTTTGGTAAGCAGAACTGGCGATGCGGGATGAACCGAACGCGAGGTTAAGGTGCCGGAGTAGACGCTCATCAGACACCACAAAAGGTGTTAGTACATTATGACAATAGGACGGTGGCCATGGAAGTCGGAATCCGCTAAGGACTGTGTAACAACTCACCTATCGAATGTACTAGCCCTGAAAATGGATGGCGCTCAAGCGTCTCACCCATACCTCGCCCTCAGGGTAGAAACGATGCCCTGAGGAGTAGGCGGACGTGGAG >UAMH06417_AY489640_RNApol2 GTCAAGAAGATCTTGGAGATTGTCTGCCATAACTGCAGCAGGGTAGTGACGAGGGAAGAAGTTCGTCTTACTTTCCTCCAGGATTGTTGCAGACCATCTTGATACTAATCGGACATCTATAGGATGAGGCCGAATTGAACGCTGCCTTCAGTACTCGCGACCCCAAGGTTCGTTTCAACCGAGTCTGGGCCATTTGCAAGAAGTACAACAAATGCCACACTCCCAAGGAGGAGAATGGCGACAAGAAGCGAGGGGGCTGCGGGAACATTCGACCCTTTGTCCGACAGCAGGCGCTGAAACTCACAGCCGTGTGGGAAGTCGAAGATGAGGCGGAAGCTAAGGAGGGCAGGAGAAAGAAGAAGAAGCAGACGGCAGCTCTCAGCGCTGAGAGAGTTCACGACATTCTTCGTCGAATTTCCACCGATGATCTGCAGCGGATTGGCCTGAACGCTGACTACGCCCGCCCCGAGTGGATGATCATTACAGTTCTTCCTGTTCCTCCCCCCCCGGTTCGTCCTAGTATCTCAATGGACGGTACAGGAACGGGCACTCGAAACGAGGATGACTTGACGTACAAACTCGGTGATATCATTAGAGCCAACGGTAACGTCAAGCAGGCCGTGCGCGAAGGGACGGTCGGCCATATTGTTGAAGAGTTCCAGGACCTTCTTCAATACCACGTTGCTACATA >UAMH06417_AY489680_SSU TGTAGTCCATATGCTTGTCTCAAAGATTAAGCCATGCATGTCTAAGTATAAGCAATTATACAGCGAAACTGCGAATGGCTCATTATATAAGTTATCGTTTATTTGATAGTGCCTTACTACTTGGATAACCGTGGTAATTCTAGAGCTAATACATGCTACAAGCCCTGACTTCGGAAGGGGCGTATTTATTAGATTAAAAACCAATGCCCTCTGGGCTCCTTGGTGAATCATGATAACTTCACGAATCGCACGGCCTTGCGCCGGCGATGGCTCATTCAAATTTCTTCCCTATCAACTTTCGATGTTTGGGTAGTGGCCAAACATGGTTGCAACGGGTAACGGAGGGTTAGGGCTCGACCCCGGAGAAGGAGCCTGAGAAACGGCTACTACATCCAAGGAAGGCAGCAGGCGCGCAAATTACCCAATCCCGATTCGGGGAGGTAGTGACAATAAATACTGATACAGGGCTCTTTCGGGTCTTGTAATCGGAATGAGTACAATTTAAATCCCTTAACGAGGAACAATTGGAGGGCAAGTCTGGTGCCAGCAGCCGCGGTAATTCCAGCTCCAATAGCGTATATTAAAGTTGTTGTGGTTAAAAAGCTCGTAGTTGAACCTTGGGCCTGGCTGGCCGGTCCGCCTCACCGCGTGTACTGGTCCGGCCGGGCCTTTCCCTCTGTGGAACCTCATGCCCTTCACTGGGTGTGCTGGGGAAACAGGACTTTTACTTTGAAAAAATTAGAGTGCTCCAGGCAGGCCTATGCTCGAATACATTAGCATGGAATAATAAAATAGGACGTGCGGTTCTATTTTGTTGGTTTCTAGGACCGCCGTAATGATTAATAGGGACAGTCGGGGGCATCAGTATTCAATTGTCAGAGGTGAAATTCTTGGATTTATTGAAGACTAACTACTGCGAAAGCATTTGCCAAGGATGTTTTCATTAATCAGGAACGAAAGTTAGGGGATCGAAAACGATCAGATACCGTTGTAGTCTTAACCATAAACTATGCCGACTAGGGATCGGACGATGTTATTTTTTGACTCGTTCGGCACCTTACGAGAAATCAAAGTGCTTGGGCTCCAGGGGGAGTATGGTCGCAAGGCTGAAACTTAAAGAAATTGACGGAAGGGCACCACCAGGGGTGGAGCCTGCGGCTTAATTTGACTCAACACGGGGAAACTCACCAGGTCCAGACACAATGAGGATTGACAGATTGAGAGCTCTTTCTTGATTTTGTGGGTGGTGGTGCATGGCCGTTCTTAGTTGGTGGGGTGACTTGTCTGCCTAATCGCGATAACGAACGAGACCTTAACCTGCTAAATAGCCCGTATTGCTTTGGCAGTACGCTGGCTTCTTAGAGGGACTATCGGCGCAAGCCGATGGAAGTTTGAGGCAATAACAGGTCTGTGATGCCCTTAGATGTCCTGGGCTGCACGCGCGTTACACTGACGGAGCCAGCGAGTACTTCCTTGTCCGAAAGGTCCGGGTAATCTTGTTAAACTCCGTCGTGCTGGGGATAGAGCATTGCAATTATTGCTCTTCAACGAGGAATCCCTAGTAAGCGCAAGTCATCAGCTTGCGTTGATTACGTCCCTGCCCTTTGTACACACCGCCCGTCGCTACTACCGATTGAATGGCTTAGTGAGGCGTTCGGACTGGTCCAGGGAGGTGGGCAACTACCACCCAGGACCGGAAAGTTCTCCAAACTTGGTCATTTAGAGGAAGTAAAAGTCGTAACAAGGTCTCCGTAGGTGAACCTGCGG >UAMH06417_AF206273_SSU-LSU CGCCCGTCGCTACTACCGATTGAATGGCTTAGTGAGGCGTTCGGACTGGTCCAGGGAGGTGGGCAACTACCACCCAGGACCGGAAAGTTCTCCAAACTTGGTCATTTAGAGGAAGTAAAAGTCGTAACAAGGTCTCCGTTGGTGAACCAGCGGAGGGATCATTACCGAGTTTACAACTCCCAAACCCTTATGTGAACCGTACCTATCGTTGCTTCGGCGGGAACGCCCCGGCGCCCTGCGCCCGGATCCAGGCGCCCGCCGGAGACCCCAAACTCTTGTGTTTTTTTCAGTATTCTCTGAGTGGCAAACGCAAAAATAAATCAAAACTTTTAACAACGGATCTCTTGGCTCTGGCATCGATGAAGAACGCAGCGAAATGCGATAAGTAATGTGAATTGCAGAATTCAGTGAATCATCGAATCTTTGAACGCACATTGCGCCCGTTAGCATTCTAGCGGGCATGCCTGTCCGAGCGTCATTTCAACCCTCAGGGTCCCCGTTCCGGCGGGGAACCTGGTGTTGGGGATCGGCCCGCCCCGTGCGGCGCCGTCCCCCAAATTCAGTGGCGGTCTCGCTGCAGCCTCCCCTGCGTAGTAGTTACAACCTCGCATCGGAGCTCAGCGCGGCCACGCCGTAAAACCCCCGACTTTCTGAACGTTGACCTCGGATCAGGTAGGAATACCCGCTGAACTTAAGCATATCAATAAGCGGAGGAAAAGAAACCAACAGGGATTGCCTT |
IMAGES: